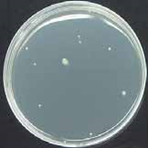

Introduction of the silver ion antibacterial effect against various organisms
It is said that silver has an anti-effect against bacteria, germs, viruses and so on.
In ancient times, people used silver for food preservative.
Also, silver nitrate has been used as a treatment for burn for the purpose of prevention of secondary infection, and used for maintaining water quality thanks to its anti-bacterial effect.
It seems that people know silver has an antibacterial effect from their experience. However, the efficacy was found when Raulin found that Aspergillus niger could not grow on silver dishes in 1869.
In the past, silver itself was used as an anti-bacterial agent, but in recent years, it has been found that applying silver ion to carriers like zeolite enables anti-bacterial effect to keep longer. This silver ion -carrier agent is less expensive and has been widely accepted.
This technology is used for various things such as knob, handrail in public space and other common goods.
The mechanism of the antibacterial effect of silver ion is that once silver ion is taken by cells, it binds to various cellular components like DNA, cell membrane and so on, and inhibits various cell functions including ATP production by forming complexes.
It is known that other metals like gold, copper, zinc, mercury, lead, cadmium and so on have anti-bacterial effect too, but some of them are harmful for human body (except gold, copper, zinc and so on). Silver is less expensive, widely used, stable, and has stronger antibacterial effect and has lower toxicity than other metals according to laboratory tests. This is why silver is thought to be the best material for anti-bacterial material.
In cell culture with CO2 incubator, it is necessary to prevent culture medium from evaporating and humidify the incubator in order to mimic biological environment in mammalian body, so the chamber of CO2 incubator is usually humidified with water tray.
Although humidification is essential for cell culture, water could be a source of contamination risks. If bacteria, mold, or other contaminants grows in water tray, cultured cells could be contaminated.
Therefore, keeping water quality clean is very important in terms of decreasing contamination risks. In this blog, let us introduce our silver ion product for CO2 incubator and show the test results of anti-bacterial effect of silver ion containing water.*
*Note: The tests were done by using water containing silver ion, not Ag+goods.
Test of antibacterial effect of silver ion on general bacteria at two concentrations.
Overview
Experimental objective: Test the antibacterial effect of silver ion at two concentrations using general bacteria. Date: December 1, 2009 Experimental Method:
- Prepare 3 different 1L experimetal liquid based on pure water as follows.
A: Saline (control)
B: Silver ion water at 0.1ppm
C: Silver ion water at 5.0ppm - Pour general bacteria suspension into each vessel of A, B and C.
- Obtain sample fluid from each vessel for 5 times (as listed below) and spreading the samples on agar medium.
a) Immediately after pouring the bacteria suspension.
b) 15 minutes after pouring the bacteria suspension.
c) 1 hour after pouring the bacteria suspension.
d) 3 hours after pouring the bacteria suspension.
e) 24 hours after pouring the bacteria suspension
Result
| Item / Sample | A | B | C |
|---|---|---|---|
| a) |  |
 |
 |
| a) Bacterial count | 4.0 × 103 / mL | 1.4 × 103 / mL | 13 / mL |
| b) |  |
 |
 |
| b) Bacterial count | 3.5 × 103 / mL | 3.0 × 102 / mL | 10 / mL |
| c) |  |
 |
|
| c) Bacterial count | 3.0 × 103 / mL | 3.0 × 102 / mL | 10 / mL |
| d) |  |
 |
 |
| d) Bacterial count | 2.0 × 103 / mL | 18 / mL | 3 / mL |
| e) |  |
 |
 |
| e) Bacterial count | 1.3 × 103 / mL | 10 / mL | 2 / mL |
Test method: Standartd agar medium method.
Discussion:
A: A lot of bacteria were viable even after 24 hours passed.
B: Viable bacteria decreased immediately after pouring bacterial suspension. 99% of bacteria were killed within 1 to 3 hours. Due to sustained effect of silver ion, bacteria did not regrow during the test period.
C: 99% of bacteria were killed immediately after pouring bacterial suspension. The 5.0 ppm liquid had greater antibacterial effect than the 0.1 ppm liquid.
Test of antibacterial effect of silver ion on E. Coli at two concentrations.
Overview
Experimental objective: Test the antibacterial effect of silver ion at two concentrations using E. Coli.
Date: December 1, 2009
Experimental Method:
- Prepare 3 different 1L experimetal liquid based on pure water as follows.
A: Saline (control)
B: Silver ion water at 0.1ppm
C: Silver ion water at 5.0ppm - Pour E. Coli suspension into each vessel of A, B and C.
- Obtain sample fluid from each vessel for 5 times (as listed below) and spreading the samples on agar medium.
a) Immediately after pouring the E. Coli suspension.
b) 15 minutes after pouring the E. Coli suspension.
c) 1 hour after pouring the E. Coli suspension.
d) 3 hours after pouring the E. Coli suspension.
e) 24 hours after pouring the E. Coli suspension
Result
| Item / Sample | A | B | C |
|---|---|---|---|
| a) |  |
 |
 |
| a) Bacterial count | 2.4 × 103 / mL | 3.9 × 10 / mL | 0 / mL |
| b) |  |
 |
 |
| b) Bacterial count | 1.6 × 103 / mL | 0 / mL | 0 / mL |
| c) |  |
 |
 |
| c) Bacterial count | 7.2 × 102 / mL | 0 / mL | 0 / mL |
| d) |  |
 |
 |
| d) Bacterial count | 5.0 × 102 / mL | 0 / mL | 0 / mL |
| e) |  |
 |
 |
| e) Bacterial count | 1.5 × 10 / mL | 0 / mL | 0 / mL |
Test method: Standard agar medium method
Discussion:
A: A lot of E.coli were viable even afer 24 hours passed.
B: Viable E. Coli decreased immediately after pouring E. Coli suspension into the water containing silver ion, then no E. Coli was detected after 15 minutes passed from the start of the test.
C: No E. Coli was detected in all samples the start of the test through the finish.
Test of antibacterial effect of silver ion on Legionella at two concentrations.
Overview
Experimental objective: Test the antibacterial effect of silver ion at two concentrations using Legionella.
Date: December 1, 2009
Experimental Method:
- Prepare 3 different 1L experimetal liquid based on pure water as follows.
A: Pure water (control)
B: Silver ion water at 0.1ppm
C: Silver ion water at 5.0ppm - Pour Legionella suspension into each vessel of A, B and C.
- Obtain sample fluid from each vessel for 5 times (as listed below) and spreading the samples on agar medium.
a) Immediately after pouring the Legionella suspension.
b) 15 minutes after pouring the Legionella suspension.
c) 1 hour after pouring the Legionella suspension.
d) 3 hours after pouring the Legionella suspension.
e) 24 hours after pouring the Legionella suspension
Result
(CFU = Colony Forming Unit)
| Item / Sample | A | B | C |
|---|---|---|---|
| a) |  |
 |
 |
| a) Bacterial count | 5.0 × 104 CFU / 100mL | 3.0 × 104 CFU / 100mL | Not detected |
| b) |  |
 |
 |
| b) Bacterial count | 5.0 × 104 CFU / 100mL | 6.2 × 103 CFU / 100mL | Not detected |
| c) |  |
 |
 |
| c) Bacterial count | 5.0 × 104 CFU / 100mL | 2.0 × 10 CFU / 100mL | Not detected |
| d) |  |
 |
 |
| d) Bacterial count | 3.5 × 104 CFU / 100mL | Not detected | Not detected |
| e) |  |
 |
 |
| e) Bacterial count | 8.1 × 103 CFU / 100mL | Not detected | Not detected |
Test method: Legionella, Filtration concentration method
Discussion:
A: Since pure water (control) did not contain any nutrition, bacteria starts decreaseing after 3 hours passed from the start. However, under usual environment, it is expected that Legionella grows as time passes.
B: Viable Legionella decreased immediately after pouring Legionella fluid into the water containing silver ion at 0.1ppm. No Legionella was detected within 1 – 3 hours.
C: No Legionella was detected from the start. It seemed that the 5.0 ppm silver ion water has greater effect than the 0.1 ppm silver ion water.
As shown above, it was found that water containing silver ion has an antibacterial effect.
Our Ag+goods! can keep water quality clean up to 6 months* due to its antibacterial effect by just putting it in water.
(* It could be shorter depending on usage condition.)
Why don’t you control contamination risks and protect your precious cells from contamination with our Ag+goods?
